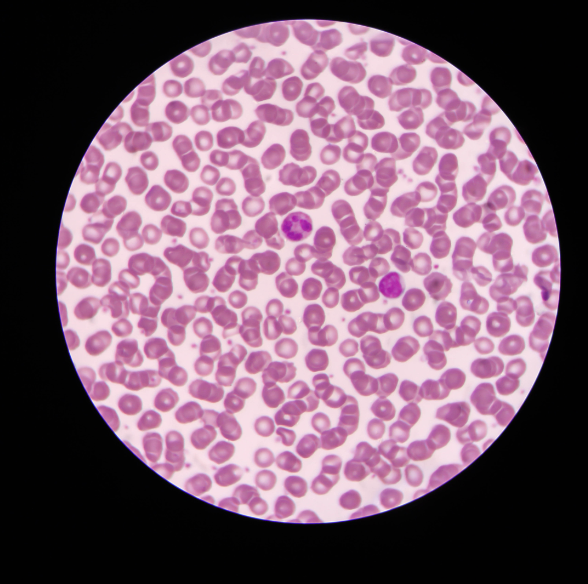
b3fb0b15-7354-471a-b60e-327f1cf9b997.png

| I couldn’t believe my ears.
I’ve known for years that most of the world’s vaccines have been produced in China…
And that vaccine materials were grown inside chicken eggs.
But, what I didn’t know…
Was that China secretly created snake villages where they could harvest millions of low-cost snake eggs to produce vaccines, cheaper and faster.
Dr. Ardis’ next comment sent chills down my spine:
“If they are harvesting vaccines from snake eggs, that means the proteins of reptiles will be in your vaccines.”
He told me that the University of Arizona published research in the summer of 2021 where they evaluated 300 C0V!D patients who had died in hospitals.
“The title of the article is, “Like Venom Coursing Through the Body.”
Dr. Ardis went on to say:
“Researchers discovered the biomarker indicating mortality in C0V!D-19 patients, and it’s an enzyme found in rattlesnake venom. That’s what they published.
“This substance is called phospholipase A2.
“And they published that every medical doctor around the world should be looking for phospholipase A2 as a biomarker to look in the blood for as the patients in your hospital that as that’s going up, the patient’s going to die because this enzyme found in rattlesnake venom destroys multiple organs at once, and they will develop multiple organ failure and die.
“Now, they published it was 20 times higher in C0V!D-19 patients than any other group of individuals that they’d ever seen with any chronic illnesses outside of C0V!D even. So those with autoimmune diseases, congestive heart failure, diabetes, and in the elderly, they see sometimes low levels of phospholipase A2. But they’d never seen it. It was 20 times higher in the C0V!D patients than they’ve ever recorded in a human.
Given what we’ve learned about the C0V!D bioweapons and the Global Elites’ population control agenda, Dr. Ardis’ next questions made perfect sense:
“How do you know there’s not snake-based phospholipase A2 protein that’s being extracted from these snake eggs in their vaccine manufacturing and they’re injecting them inside of you? You’re developing diseases, chronic illnesses, and they’re finding low levels of phospholipase A2. How do you know those weren’t introduced inside of you when you received your vaccine?
“This would explain a whole bunch of the chronic illnesses that individuals are living with. If they have figured out how to get snake protein into humans, they have created a new narrative that there’s this new enzyme.
“How did a venom, a venom component called phospholipase A2, which was first ever discovered in a snake, how is it now in low levels of all chronically ill people?” |
![]()
![]()